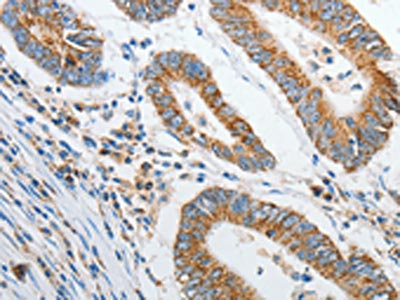

PRDX1 Antibody
-
中文名稱:PRDX1兔多克隆抗體
-
貨號:CSB-PA912013
-
規格:¥1100
-
圖片:
-
The image on the left is immunohistochemistry of paraffin-embedded Human liver cancer tissue using CSB-PA912013(PRDX1 Antibody) at dilution 1/20, on the right is treated with synthetic peptide. (Original magnification: ×200)
-
The image on the left is immunohistochemistry of paraffin-embedded Human colon cancer tissue using CSB-PA912013(PRDX1 Antibody) at dilution 1/20, on the right is treated with synthetic peptide. (Original magnification: ×200)
-
Gel: 12%SDS-PAGE, Lysate: 40 μg, Lane 1-7: Mouse liver tissue, NIH/3T3 cells, RAW264.7 cells, 293T cells, K562 cells, Jurkat cells, hela cells, Primary antibody: CSB-PA912013(PRDX1 Antibody) at dilution 1/400, Secondary antibody: Goat anti rabbit IgG at 1/8000 dilution, Exposure time: 50 seconds
-
-
其他:
產品詳情
-
Uniprot No.:
-
基因名:
-
別名:Heme binding 23 kDa protein antibody; MSP23 antibody; Natural killer cell-enhancing factor A antibody; NKEF A antibody; NKEF-A antibody; NKEFA antibody; OSF3 antibody; Osteoblast specific factor 3 antibody; PAG antibody; Paga antibody; PAGB antibody; Peroxiredoxin 1 antibody; Peroxiredoxin-1 antibody; PRDX1 antibody; PRDX1_HUMAN antibody; Proliferation associated gene A antibody; Proliferation-associated gene protein antibody; PRX1 antibody; PrxI antibody; TDPX2 antibody; Thioredoxin peroxidase 2 antibody; Thioredoxin-dependent peroxide reductase 2 antibody
-
宿主:Rabbit
-
反應種屬:Human,Mouse,Rat
-
免疫原:Synthetic peptide of Human PRDX1
-
免疫原種屬:Homo sapiens (Human)
-
標記方式:Non-conjugated
-
抗體亞型:IgG
-
純化方式:Antigen affinity purification
-
濃度:It differs from different batches. Please contact us to confirm it.
-
保存緩沖液:-20°C, pH7.4 PBS, 0.05% NaN3, 40% Glycerol
-
產品提供形式:Liquid
-
應用范圍:ELISA,WB,IHC
-
推薦稀釋比:
Application Recommended Dilution ELISA 1:1000-1:2000 WB 1:200-1:1000 IHC 1:25-1:100 -
Protocols:
-
儲存條件:Upon receipt, store at -20°C or -80°C. Avoid repeated freeze.
-
貨期:Basically, we can dispatch the products out in 1-3 working days after receiving your orders. Delivery time maybe differs from different purchasing way or location, please kindly consult your local distributors for specific delivery time.
-
用途:For Research Use Only. Not for use in diagnostic or therapeutic procedures.
相關產品
靶點詳情
-
功能:Thiol-specific peroxidase that catalyzes the reduction of hydrogen peroxide and organic hydroperoxides to water and alcohols, respectively. Plays a role in cell protection against oxidative stress by detoxifying peroxides and as sensor of hydrogen peroxide-mediated signaling events. Might participate in the signaling cascades of growth factors and tumor necrosis factor-alpha by regulating the intracellular concentrations of H(2)O(2). Reduces an intramolecular disulfide bond in GDPD5 that gates the ability to GDPD5 to drive postmitotic motor neuron differentiation.
-
基因功能參考文獻:
- Even low doses of radiation employed for dental purposes are capable to provoke stress to cells, which was demonstrated via the induction of the antioxidant gene PRDX1. In elderly patients, such mechanism was demonstrated to be impaired. PMID: 29063384
- PRDX1 expression is low in osteosarcoma and fibrosarcoma tumors. PRDX1 suppressed the progression and metastasis of osteosarcoma and fibrosarcoma cells. PMID: 29908016
- that Peroxiredoxin1 expression predicted poor prognosis by regulating the tumor metastasis and angiogenesis of colorectal cancer PMID: 29673884
- The mRNA and protein levels of Prdx1 in the GC tissues were higher than in the peri-tumor tissues. Authors also found that high Prdx1 expression was positively correlated with the lymph node invasion and poor prognosis. PMID: 29656298
- these data ascertain the existence of an H2O2-sensitive PRDX1-FOXO3 signaling axis that fine tunes FOXO3 activity toward the transcription of gene targets in response to oxidative stress. PMID: 28398822
- Study uncovered a novel interaction between APE1 and PRDX1, which existed in both the nuclear and cytosolic fractions. Its knockdown enhances APE1 detection in the nucleus and stimulates IL-8 expression. Also, in gastric cancer patients, PRDX1 mRNA expression level is reduced and correlates with poor survival. PMID: 27388124
- Median PRDX1 levels were significantly higher in stroke patients compared to controls. PMID: 27924073
- The epimutation is present in three generations and results from PRDX1 mutations that force antisense transcription of MMACHC. PMID: 29302025
- Peroxiredoxin I (Prx I) increased in tumors of hepatocellular carcinoma (HCC) patients that aligned with overexpression of oncogenic H-ras. PMID: 27517622
- Prx1 might play an oncogenic role in tobacco-related oral squamous cell carcinoma and thus serve as a target for chemopreventive and therapeutic interventions. PMID: 27259998
- PRDX1 safeguards telomeres from oxygen radicals to counteract telomere damage and preserve telomeric DNA for elongation by telomerase. PMID: 28009281
- infection results in S-nitrosylation of multiple host proteins, including Prx1. PMID: 27612662
- circulating Prdx1 provides not only prognostic information but may be a promising target against ischemia/reperfusion injury. PMID: 27142532
- our findings suggest that the tumor suppressor activity of SIRT2 requires its ability to restrict the antioxidant activity of Prdx-1, thereby sensitizing breast cancer cells to reactive oxygen species -induced DNA damage and cell cytotoxicity PMID: 27503926
- UV-vis spectra of heme-PRX1 suggested that Cys52 is the axial ligand of ferric heme. PRX1 peroxidase activity was lost upon heme binding, reflecting the fact that Cys52 is not only the heme-binding site but also the active center of peroxidase activity. PMID: 28082197
- Prx1 and Prx2 are likely targets of urate hydroperoxide in cells. Oxidation of Prxs by urate hydroperoxide might affect cell function and be partially responsible for the pro-oxidant and pro-inflammatory effects of uric acid. PMID: 28348082
- Data suggest that PRX1 is a dual-function enzyme exhibiting both thioredoxin peroxidase-like activity and catalase-like activity with varied affinities towards reactive oxygen species; studies were conducted using recombinant proteins from green spotted puffer fish Tetraodon nigroviridis and from human. PMID: 28219939
- peroxiredoxin 1 has a role in redox sensing and transducing [review] PMID: 27756681
- Activation of PRX1 and -2 indicate cold atmospheric plasma affects redox homeostasis in osteosarcoma cells PMID: 28314261
- Data show that peroxiredoxins PRDX1 and PRDX2 are upregulated in tumor B cells as compared with normal counterparts. PMID: 26636537
- Data show the protein partners of human Prx1 and Prx2 and identified three sequence motifs, or combination thereof in Prxs partners, namely: CXXC, PXXP, and LXXLL. that can be important for protein localization, function and biological pathways. [review] PMID: 26548861
- The data indicate that Prdx1 may contribute to the development and progression of hilar cholangiocarcinoma PMID: 26617696
- Our data suggest that PRX1 inactivation could represent an interesting strategy to enhance cancer cell sensitivity to vitK3, providing a potential new therapeutic perspective for this old molecule. PMID: 26689287
- TRX-1/PRX-1 levels are associated with NADPH oxidase-activity in vivo and in vitro in atherosclerosis. PMID: 26117319
- PRDX1 was overexpressed in the tumor tissues of liver cancer and served as an independent poor prognostic factor for overall survival. PRDX1 can be modified by small ubiquitin-like modifier to play specific roles in hepatocarcinogenesis. PMID: 26478675
- The immunohistochemistry-based validation using tissue microarray slides in oral squamous cell carcinoma revealed overexpression of the RAB2A and PRDX1 gene in 80 and 68 % of the tested clinical cases, respectively. PMID: 26159854
- the protein and mRNA levels of PRDX1 were significantly elevated under insulin-resistant conditions PMID: 26301632
- Prdx1 associates with the formation of membrane protrusions through modulation of the activity of p38 MAPK, which in turn promotes pancreatic ductal adenocarcinoma cell invasion. PMID: 25426613
- These findings that Prdx1 may be involved in tumorigenesis in esophageal squamous cell carcinoma PMID: 25579166
- Dephosphorylation of PrxI by okadaic acid-sensitive phosphatases during late mitosis again shields the centrosome from H2O2 and thereby allows the reactivation of Cdk1-opposing phosphatases at the organelle. PMID: 26150388
- This review will summarize the molecular basis of differences in the affinity of Srx for individual Prx and the role of individual component of the Srx-Prx system in tumor progression and metastasis. PMID: 26170166
- Overexpression of PRDX1 resulted in a higher resistance of cells to BCNU treatment PMID: 25484280
- PRDX1 is shown to be an independent predictor of improved outcomes in ER-positive breast cancer. PMID: 25011585
- The K(27)-acetylated hPrx1 exhibited greatly enhanced chaperone activity (e.g. protecting the protein malate dehydrogenase (MDH) from thermally induced aggregation and assisting the refolding of denatured citrate synthase). PMID: 25082442
- High level of PRDX1 expression is associated with lymph node metastasis and lung tumor differentiation. PMID: 23914992
- MicroRNA-510 promotes cell and tumor growth by targeting peroxiredoxin1 in breast cancer. PMID: 23971998
- because of the lower amount of total PRDX1 and PRDX6 and the high thiol oxidation of these PRDXs, very little (less than 20%) protection due to PRDXs remains in infertile men, and this is associated with impaired sperm function and poor DNA integrity PMID: 22492841
- Hypoexpression of PRDX1 is associated with papillary thyroid carcinomas. PMID: 24316730
- increased Prdx1 expression is associated with tumor angiogenesis and progression in hepatocellular carcinoma PMID: 24297309
- results suggest that NGF-trkA signaling is involved in mechanical allodynia in paclitaxel-induced neuropathy PMID: 24480440
- The data indicate that Prdx1 may contribute to malignant transformation of the esophagus, and may be used as a biomarker in the immunodiagnosis of ESCC. PMID: 24009050
- cellular distribution of Peroxiredoxin I and II in human eyes PMID: 24152995
- Thioredoxin 1 is inactivated due to oxidation induced by peroxiredoxin under oxidative stress and reactivated by the glutaredoxin system. PMID: 24062305
- Our findings suggest that Prx1 may modulate the chemosensitivity of lung cancer to docetaxel through suppression of FOXO1-induced apoptosis. PMID: 23615915
- Prdx1 orchestrates redox signaling in an H2O2 dose-dependent manner through the oxidation status of its peroxidatic cysteine Cys52. PMID: 23334324
- Data indicate that AMP-dependent kinases (AMPKalpha1 and AMPKalpha2) inhibit caveolin-1 phosphorylation by stabilizing the interaction between c-Abl and Prdx-1. PMID: 23723070
- study identified Pin1 as a novel PRDX1 binding protein and proposed a mechanism for Pin1 in regulating the metabolism of reactive oxygen species in cells PMID: 23421996
- expression of Prxs I and IV, both at mRNA and protein levels, was associated with light chain secretion quantified by ELISA. PMID: 23737084
- observations suggest that PRDX1 acts as a pro-cancer protein in HCC HepG2 cells. PMID: 23277276
- The protein and mRNA expressions of Prx1 and Prx6 increased significantly in the order of normal brain tissue, grade II astrocytoma, grade III astrocytoma and grade IV astrocytoma. PMID: 22985558
顯示更多
收起更多
-
亞細胞定位:Cytoplasm. Melanosome. Note=Identified by mass spectrometry in melanosome fractions from stage I to stage IV.
-
蛋白家族:Peroxiredoxin family, AhpC/Prx1 subfamily
-
數據庫鏈接:
Most popular with customers
-
YWHAB Recombinant Monoclonal Antibody
Applications: ELISA, WB, IHC, IF, FC
Species Reactivity: Human, Mouse, Rat
-
Phospho-YAP1 (S127) Recombinant Monoclonal Antibody
Applications: ELISA, WB, IHC
Species Reactivity: Human
-
-
-
-
-
-